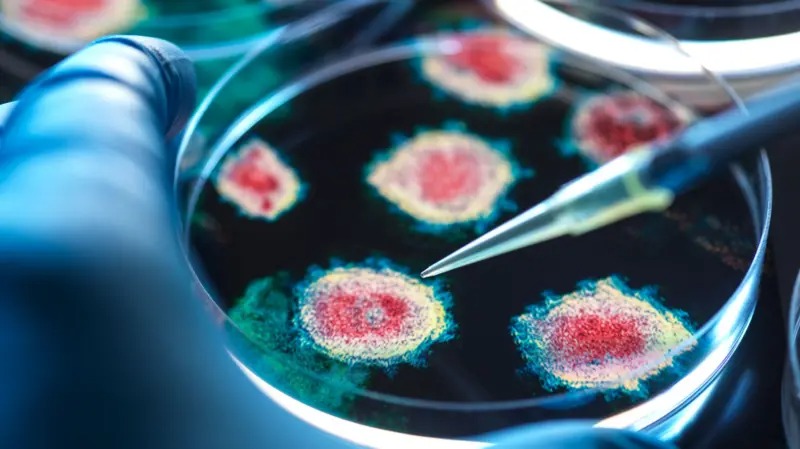

चमेरोमा भेटियो नयाँ भाइरस, कोभिड–१९ जस्तै मानिसमा पनि फैलिने जोखिम
23rd February, 2025 Sun १५:५९:३२ मा प्रकाशित
काठमाडौं । चिनियाँ अनुसन्धानकर्ताहरूले चमेरोमा नयाँ कोरोनाभाइरस पत्ता लागेको बताएका छन् जसले कोभिड–१९ संक्रमण निम्त्याउने सार्स सीओभी–२ भाइरस जस्तै काम गर्छ।
समाचार एजेन्सी रोयटर्सका अनुसार यो भाइरसले मानव शरीरमा प्रवेश गर्न सार्स सीओभी–२ भाइरस जस्ता कोष सतह प्रोटिनहरू प्रयोग गर्दछ।
यसपछि, कुनै दिन यो भाइरस मानिसहरूमा फैलिन सक्छ कि भन्ने चिन्ता बढेको छ।
यद्यपि, चिनियाँ अनुसन्धानकर्ताहरूले भनेका छन् कि यो नयाँ भाइरस सार्स सीओभी–२ जत्तिकै सजिलै मानव शरीरमा प्रवेश गर्दैन।
समाचार एजेन्सी पीटीआईले यो अध्ययनको नेतृत्व चिनियाँ वैज्ञानिक शि झेंगलीले गरेको बताएको छ, जसले विवादास्पद वुहान इन्स्टिच्युट अफ भाइरोलोजीमा पनि काम गरिसकेकी छिन्।
यो अध्ययन सेल नामक वैज्ञानिक जर्नलमा प्रकाशित भएको छ। यसमा यो नयाँ भाइरसको नाम एचकेयु ५–सीओभी–२ भनिएको छ।
अमेरिकाले कोभिड(१९ भाइरस वुहानको यही प्रयोगशालाबाट उत्पन्न भएको आरोप लगाएको थियो। यद्यपि, चिनियाँ सरकारले अमेरिकाको यी आरोपहरूलाई अस्वीकार गर्दै आएको छ।

यो नेपाली भाषाको अनलाइन समाचार संस्था हो । हामी तपाईहरुमा देशविदेशका समाचार र विचार पस्कने गर्छौ । तपाईको आलोचनात्मक सुझाव हाम्रा लागी सधै ग्रह्य छ । हामीलाई पछ्याउनुभएकोमा धन्यवाद । हामीबाट थप पढ्न तल क्लिक गर्नुहोस् ।
जेष्ठ ११ गते, २०८३ - ०९:५०
हावाहुरीले ढलेका रुख, लडेको विद्युत् आपूर्ति
देशका विभिन्न क्षेत्रमा ट्रिपिङ, प्राधिकरण मर्मतमा सक्रिय
जेष्ठ ११ गते, २०८३ - ०९:२१
मधेश सरकारमा सत्ता समीकरणको नयाँ संकट
शपथ रोकियो, सहमति अलपत्र, गठबन्धनभित्रै अविश्वास
जेष्ठ ११ गते, २०८३ - ०९:१६
लुम्बिनी प्रदेशको वार्षिक नीति तथा कार्यक्रम आज पेश हुने
रूपन्देही । लुम्बिनी प्रदेश सरकारले आज आगामी आर्थिक बर्ष २०८३–८४ को नीति तथा कार्यक्रम ल्याउँदैछ । प्रदेश सभाको दिउँसो १ बजे बस्ने आठौं अधिवेशन अन्...
जेष्ठ ११ गते, २०८३ - ०९:१५
बागमती प्रदेशसभाको वर्षे अधिवेशन आजदेखि
मकवानपुर । बागमती प्रदेशसभाको वर्षे अधिवेशन आजदेखि सुरु हुँदैछ । आज दिउँसो १ः०० बजे बस्ने प्रदेशसभाको बैठकमा मुख्यमन्त्रीसहित प्रदेशमा प्रतिनिधित्व...
जेष्ठ ११ गते, २०८३ - ०८:४७
पाँच वर्षदेखि निर्माणमै अल्झिएको अस्पताल भवन नबन्दा बिरामीले भोग्दै भीड, सास्ती र अपूरो उपचार
गुल्मी । गुल्मी अस्पताल मा बिहानै बिरामीको भीड लाग्छ । कोही ज्वरो लिएर आएका हुन्छन्, कोही भिडियो एक्स–रे गराउन लाइनमा बसेका हुन्छन्, कोही आकस्मिक कक्ष...
जेष्ठ ११ गते, २०८३ - ०८:४३
ट्रकभित्रको चिच्याहटः बजारसम्म आइपुग्ने मासुको पछाडि लुकेको अमानवीय यात्रा
काठमाडौं । काठमाडौंका मासु पसलहरू बिहानै खुल्छन् । झुन्ड्याइएका खसीबाख्रा देखेर ग्राहकले मूल्य सोध्छन्, तौल गर्छन् र किनेर फर्किन्छन् । बजार चलिरहेकै ...
जेष्ठ ११ गते, २०८३ - ०८:३५
बर्खा नलाग्दै विपत्तिको संकेत
पूर्वी नेपालमा बाढीपहिरोको बितण्डा, बदलिँदो मौसमसँग जुध्न अझै तयार छैन देश
जेष्ठ ११ गते, २०८३ - ०८:३०
भारतमा इन्धनको भाउमा आगो : १० दिनमै चौथो पटक मूल्यवृद्धि, दिल्लीमा पेट्रोल १०२ रुपैयाँ नाघ्यो
काठमाडाैंं । भारत मा १० दिनभित्रै चौथो पटक पेट्रोलियम पदार्थको मूल्य बढाइएको छ । मध्यपूर्वमा चर्किएको तनाव र अन्तर्राष्ट्रिय बजारमा कच्चा तेलको मूल्यव...
जेष्ठ ११ गते, २०८३ - ०८:१७
कालीमाटीको नयाँ मूल्यसूची सार्वजनिक : गोलभेँडा ८० रुपैयाँसम्म, सिताके च्याउ १ हजार !
काठमाडौं । कालीमाटी फलफूल तथा तरकारी बजार विकास समिति ले आजका लागि कृषिउपजको अधिकतम थोक मूल्य निर्धारण गरेको छ । नयाँ मूल्यसूचीअनुसार गोलभेँडा, प्याज,...
जेष्ठ ११ गते, २०८३ - ०८:१५
खेतमा भैँसी गएको निहुँमा ६० वर्षीया दलित महिलामाथि निर्घात कुटपिट
सिरहा । सिरहामा एक दलित महिलामाथि कुटपिट गरेको आरोपमा प्रहरीले एक जनालाई पक्राउ गरेको छ । नरहा गाउँपालिका—३ का ५५ वर्षीय पवित्रनारायण यादवलाई प्रहरीले...






प्रतिकृया लेख्नुहोस्: